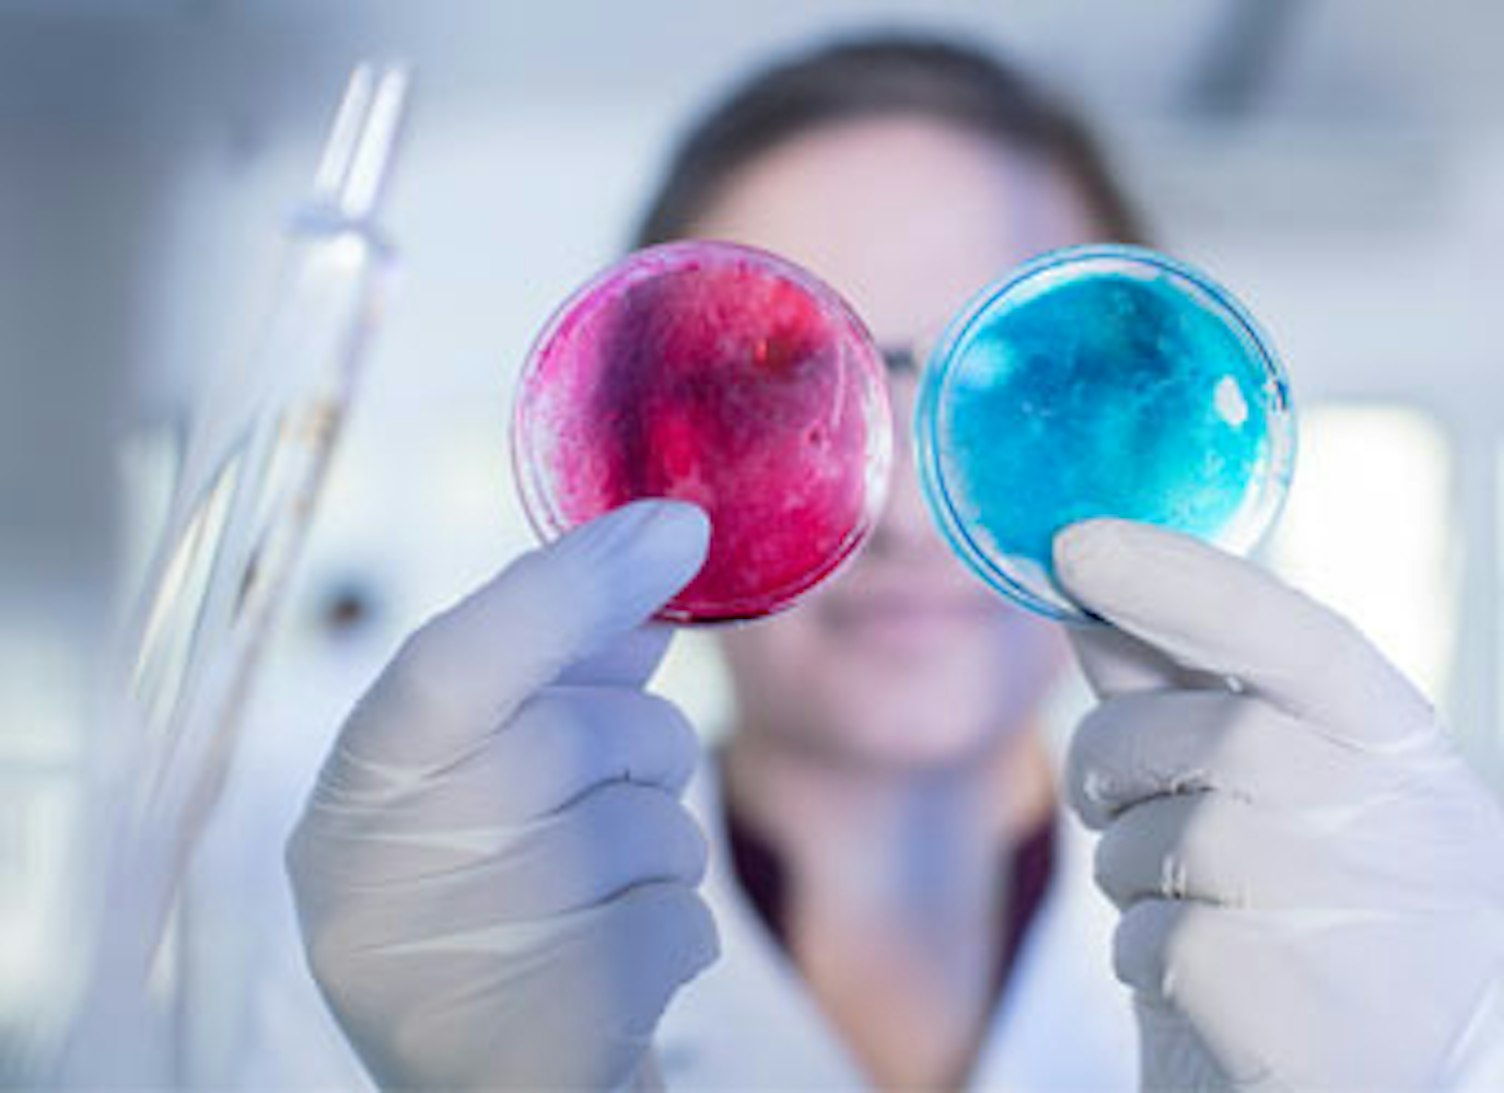
Laboratory Worker Examining Two Petri Dishes Side by Side

SGS is pleased to announce the acquisition of the lab facilities of ISL, a laboratory providing analytical services for pharmaceutical products and substances based in Ringaskiddy (Cork), Ireland.
International Service Laboratory (ISL), located on the Novartis site in Ringaskiddy, provides regulated analytical laboratory and stability testing services for a broad variety of pharmaceutical products. It is Good Manufacturing Practices (GMP) certified by the Irish health authorities (HPRA) and US FDA registered.
Following completion, 100 highly skilled employees will transfer to SGS. Post-acquisition, ISL will continue to provide pharmaceutical quality control testing and support Novartis’ major manufacturing operations. As a recognized center of excellence, ISL will also become a strategic component of SGS’s global Life Sciences laboratories network.
This acquisition is part of the SGS Group global strategy for the Life Sciences sector. It is focused on the growth and diversification of services to protect patient safety and support the evolving needs of the global healthcare industry, of which Ireland is an important strategic global hub.
Frankie Ng, CEO of SGS said: “This acquisition supports our strategic evolution by further aligning our global network more closely to the key Life Sciences TIC megatrend and customer demand. ISL adds a significant level of competence and enables us to offer increasingly complex services to our customers on a global basis.”
The acquisition is expected to close at the end of the first quarter of 2021, subject to approval from the relevant regulatory authorities and SGS obtaining the required licenses to operate the facility.
For further information, please contact:
Investors: Toby Reeks
SVP, Investor Relations, Corporate Communications and Sustainability
t: +41 79 641 83 02
Media: Daniel Rufenacht
Group VP, Corporate Communications and Sustainability
t: +41 78 656 94 59
ABOUT NOVARTIS IRELAND LIMITED
Novartis Ireland Limited is the Irish affiliate of Swiss-based Novartis AG – one of the largest pharmaceutical companies in the world. It is one of Ireland’s leading employers in the healthcare industry. One of the first pharmaceutical companies to locate in Ireland in the 1950s, Novartis has a strong history of investing in Ireland over the last 60 years. Novartis currently employs more than 1,400 people across three locations in Cork and Dublin. The company’s manufacturing and development is based in Ringaskiddy, Co Cork.
ABOUT SGS
SGS is the world's leading inspection, verification, testing and certification company. SGS is recognized as the global benchmark for quality and integrity. With more than 89,000 employees, SGS operates a network of over 2,600 offices and laboratories around the world.